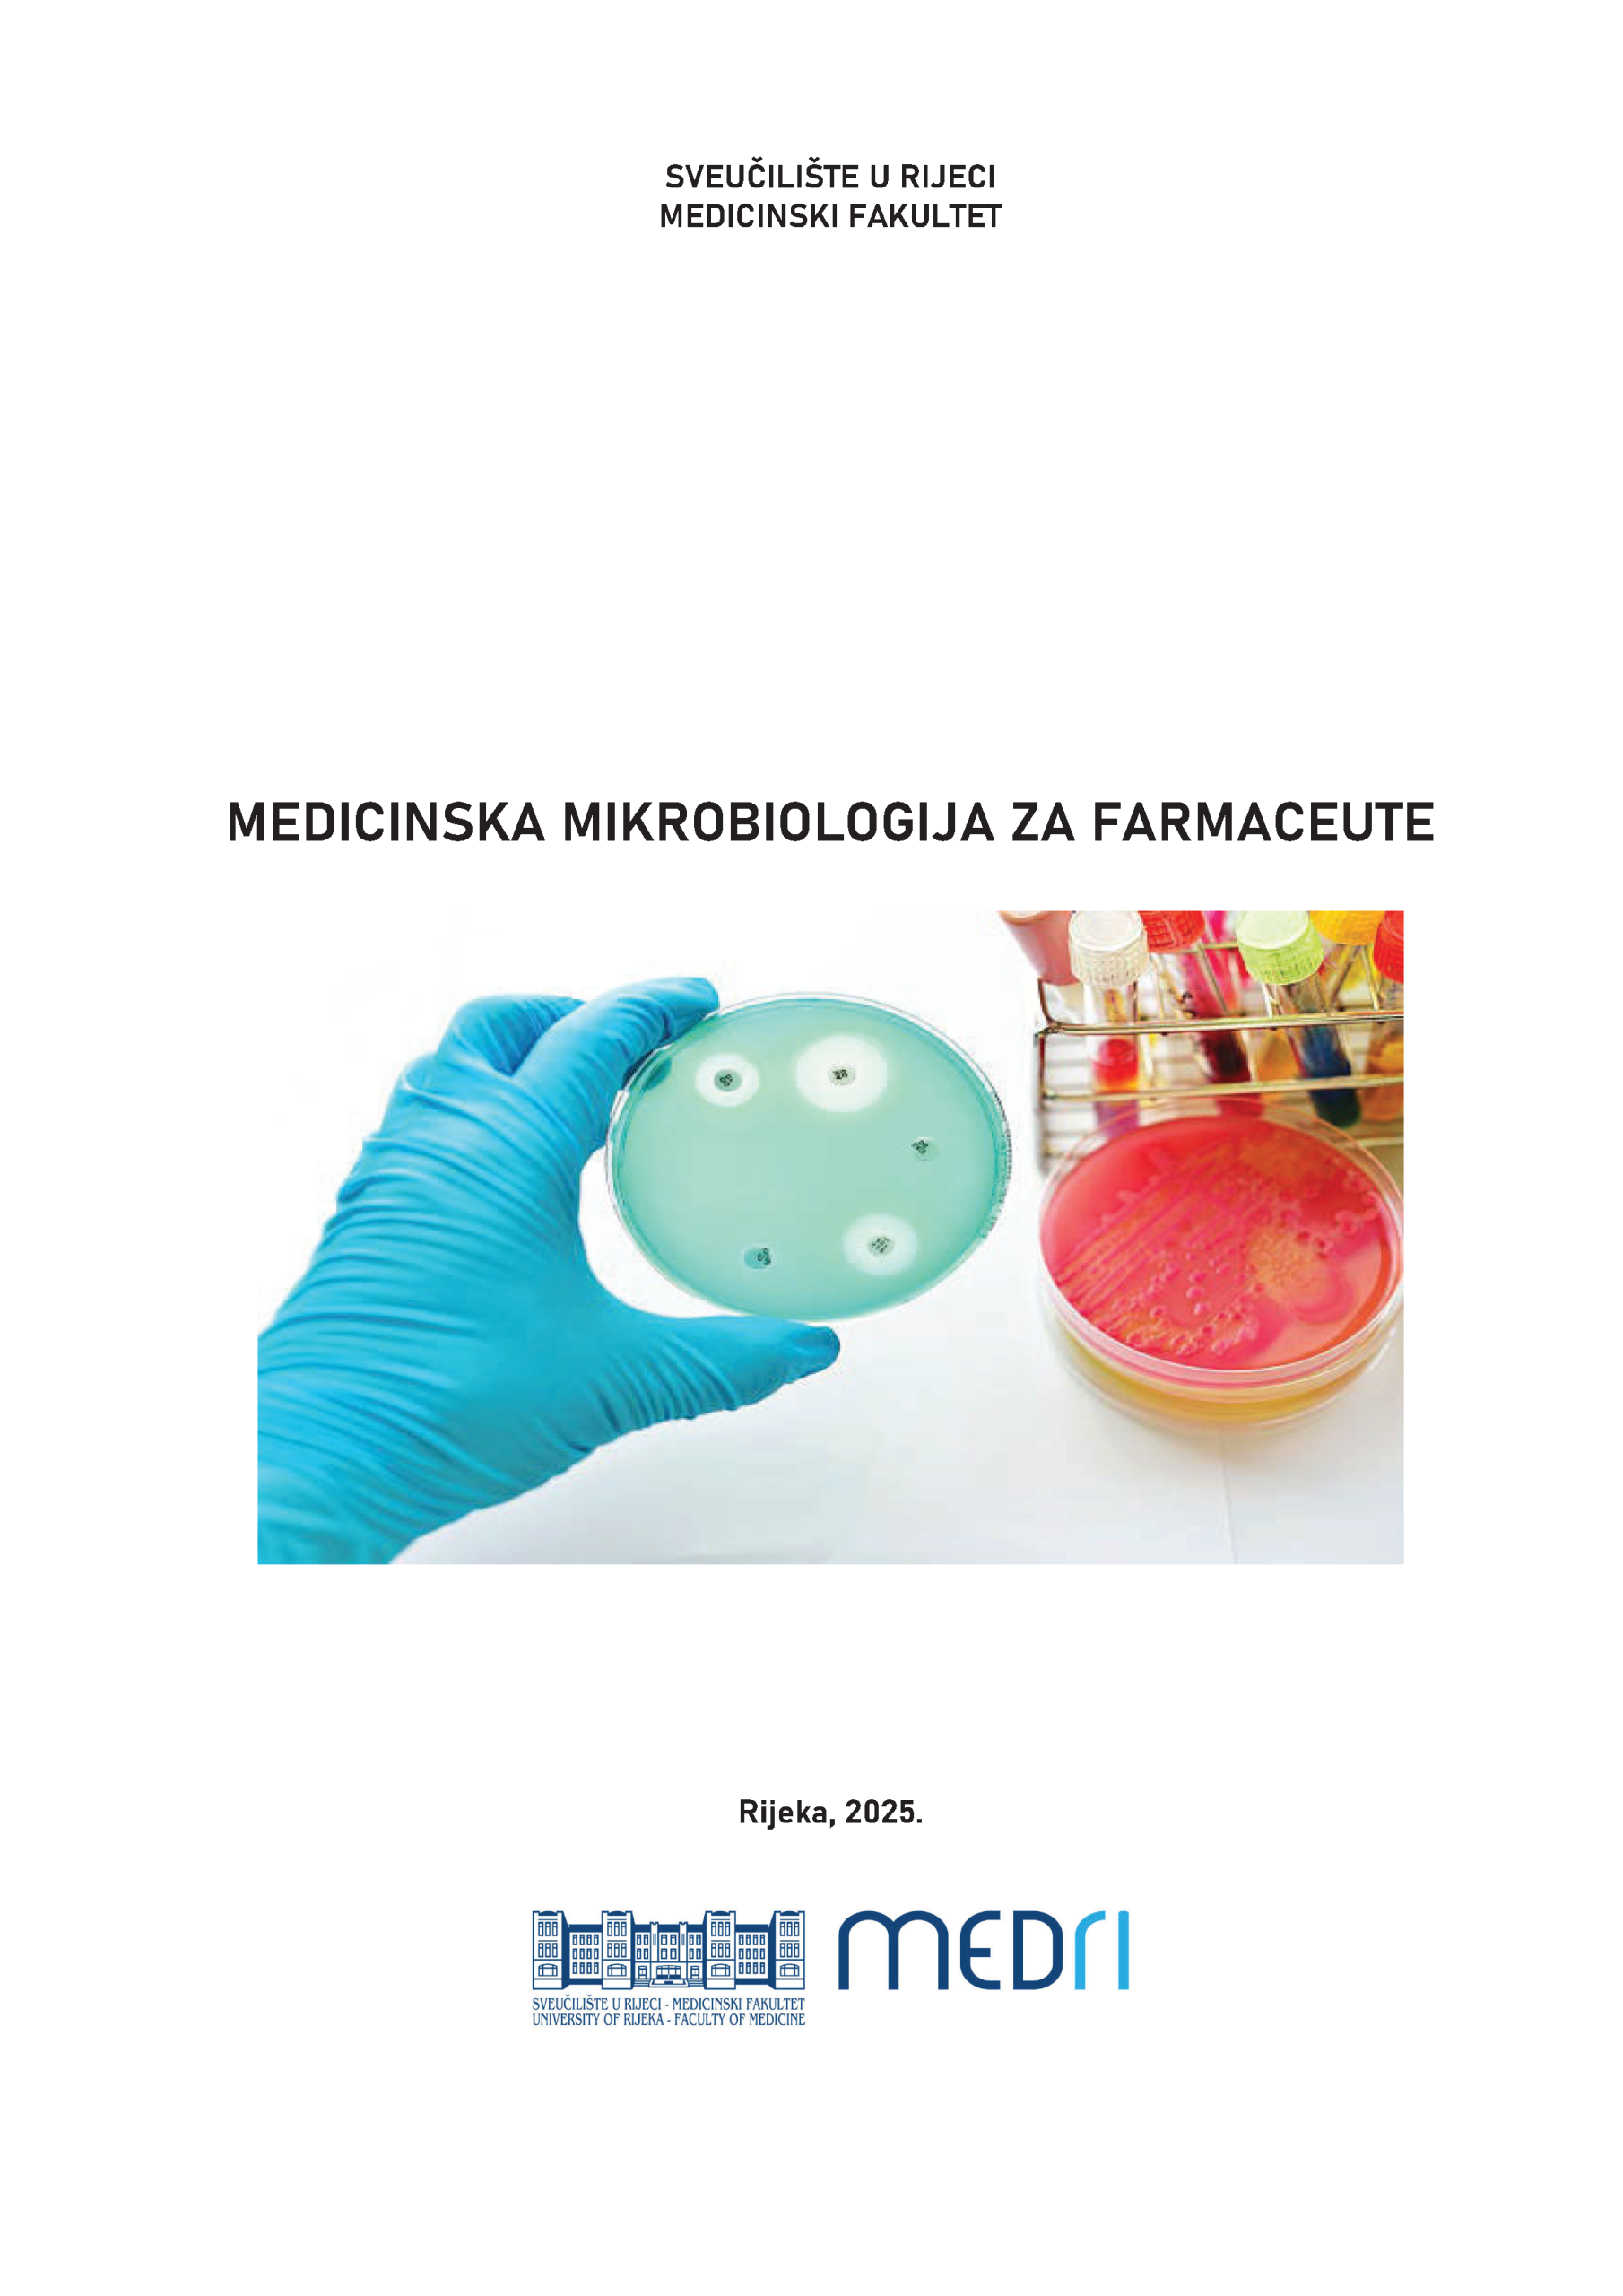

Medicinska mikrobiologija za farmaceute
Urednica: Autorice: Sažetak: Priručnik „Medicinska mikrobiologija za farmaceute“ predstavlja izvorno djelo koje je kao priručnik za vježbe prije svega namijenjeno studentima Sveučilišnog integriranog prijediplomskog i diplomskog studija Farmacija iako prema sadržaju i opsegu može poslužiti kao priručnik za praktične vježbe i na drugim studijima.Djelo obrađuje sva relevantna područja medicinske mikrobiologije i parazitologije. Poglavlja se sastoje … Nastavi čitati Medicinska mikrobiologija za farmaceute